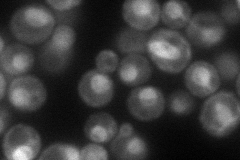
YLL053C
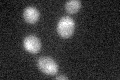
YLL053C

View description
Putative protein; in the Sigma 1278B strain background YLL053C is contiguous with AQY2 which encodes an aquaporin
Localization:
Intensity:
Fold change:
Significance:
-
C’ GFP library in SD

below threshold17.95 -
N' NOP1pr-GFP in SD
cell periphery,nucleus85.4089 -
N' TEF2pr-mCherry in SD

ER16.9742 -
N' NATIVEpr-GFP in SD

below threshold19.5783 -
N' TEF2pr-VC and Cyto-VN in SD

#N/A0 -
C’ GFP library in SD+DTT
cytosol16.950.94No -
C’ GFP library in SD+H2O2

cytosol15.260.85No -
C’ GFP library in Starvation Media

cytosol17.590.98No -
C’ GFP library on the background of Pup2-DaMP

below threshold -
C’ GFP library on the background of CCT mutant

below threshold15.68140.873416No
